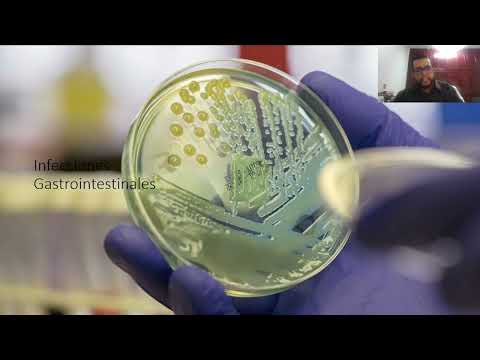

20/04/2011
Tipos de infecciones estomacales: una guía completa
Desde leves molestias hasta síntomas graves y debilitantes, las infecciones estomacales pueden afectar a cualquier persona en cualquier momento. Estas infecciones son causadas por bacterias, virus o parásitos que ingresan al sistema digestivo y pueden ser transmitidas por alimentos y agua contaminados, contacto con personas infectadas o falta de higiene adecuada.
En este artículo, te proporcionaremos información detallada sobre los diferentes tipos de infecciones estomacales, sus síntomas característicos y las mejores prácticas para tratar y prevenir estas enfermedades. Si estás buscando respuestas, ¡has llegado al lugar correcto!
Es importante destacar que esta publicación tiene fines informativos únicamente y no sustituye el diagnóstico o tratamiento médico profesional. Si tienes síntomas graves o persistentes, te recomendamos acudir a un médico para recibir atención adecuada. Ahora, comencemos con los tipos de infecciones estomacales más comunes:
- Tipos de infecciones estomacales
-
Preguntas frecuentes sobre las infecciones estomacales
- ¿Cuánto tiempo duran las infecciones estomacales?
- ¿Cuáles son los alimentos más propensos a causar infecciones estomacales?
- ¿Cómo se pueden prevenir las infecciones estomacales?
- ¿Cuándo se debe buscar atención médica por una infección estomacal?
- ¿Cuáles son los tratamientos más comunes para las infecciones estomacales?
- Conclusión
Tipos de infecciones estomacales
-
Gastroenteritis vírica
La gastroenteritis vírica, también conocida como gripe estomacal, es causada por diferentes virus, como el rotavirus y el norovirus. Esta infección se caracteriza por vómitos, diarrea y dolor abdominal.
-
Fiebre tifoidea
La fiebre tifoidea es una infección bacteriana causada por la bacteria Salmonella typhi. Los síntomas incluyen fiebre, dolor de cabeza, pérdida de apetito y malestar general.
-
Infección por Helicobacter pylori
La infección por Helicobacter pylori es una de las principales causas de úlceras estomacales. Esta bacteria puede provocar síntomas como dolor abdominal, acidez estomacal y náuseas.
-
Salmonelosis
La salmonelosis es una infección bacteriana comúnmente asociada con alimentos crudos o mal cocidos, especialmente carnes y huevos. Los síntomas incluyen diarrea, fiebre y malestar general.
-
Infección por Escherichia coli
La infección por Escherichia coli (E. coli) es causada por una bacteria que normalmente se encuentra en los intestinos de los humanos y los animales. Algunas cepas de E. coli pueden causar enfermedades graves como la colitis hemorrágica.
-
Shigelosis
La shigelosis es una infección bacteriana causada por diferentes especies de la bacteria Shigella. Se caracteriza por diarrea acuosa o con sangre, fiebre y dolor abdominal.
-
Campylobacteriosis
La campylobacteriosis es una infección bacteriana comúnmente transmitida a través de alimentos contaminados, especialmente carnes crudas y aves de corral. Los síntomas incluyen diarrea, fiebre y dolor abdominal.
-
Infección por Giardia lamblia
La infección por Giardia lamblia es una enfermedad parasitaria que afecta principalmente el intestino delgado. Los síntomas incluyen diarrea, gases y dolor abdominal.
-
Infección por Cryptosporidium
La infección por Cryptosporidium es una enfermedad parasitaria que puede afectar tanto el sistema digestivo como otros órganos, como los pulmones. Los síntomas incluyen diarrea acuosa, fiebre y dolor abdominal.
-
Vibriosis
La vibriosis es una infección bacteriana causada por diferentes especies de la bacteria Vibrio, que se encuentra principalmente en mariscos crudos o mal cocidos. Los síntomas incluyen diarrea, fiebre y dolor abdominal.
Preguntas frecuentes sobre las infecciones estomacales
-
¿Cuánto tiempo duran las infecciones estomacales?
La duración de una infección estomacal depende de varios factores, incluido el tipo de infección y la gravedad de los síntomas. En general, la mayoría de las infecciones estomacales leves mejoran en unos pocos días, mientras que las infecciones más graves pueden requerir más tiempo para recuperarse por completo.
-
¿Cuáles son los alimentos más propensos a causar infecciones estomacales?
Los alimentos más propensos a causar infecciones estomacales son aquellos que se consumen crudos o mal cocidos, como carnes, mariscos, huevos y productos lácteos sin pasteurizar. Es importante seguir prácticas de higiene adecuadas al manipular y preparar estos alimentos para reducir el riesgo de infecciones.
-
¿Cómo se pueden prevenir las infecciones estomacales?
Para prevenir las infecciones estomacales, es fundamental seguir buenas prácticas de higiene, como lavarse las manos con frecuencia, especialmente antes de comer o preparar alimentos, evitar el consumo de alimentos crudos o mal cocidos y mantener una buena higiene alimentaria en general.
-
¿Cuándo se debe buscar atención médica por una infección estomacal?
Debes buscar atención médica si presentas síntomas graves o persistentes, como fiebre alta, sangre en las deposiciones, deshidratación severa o síntomas que no mejoran después de unos días. Un médico podrá evaluar adecuadamente tus síntomas y recomendarte el tratamiento adecuado.
-
¿Cuáles son los tratamientos más comunes para las infecciones estomacales?
El tratamiento para las infecciones estomacales puede variar dependiendo del tipo y la gravedad de la infección. En general, se recomienda descansar, mantenerse hidratado, evitar alimentos irritantes y seguir una dieta suave hasta que los síntomas mejoren. En algunos casos, es posible que se requiera medicación para tratar la infección específica.
Conclusión
En resumen, las infecciones estomacales son enfermedades comunes que pueden afectar a cualquier persona. Conociendo los diferentes tipos de infecciones y comprendiendo cómo prevenirlas y tratarlas adecuadamente, podemos reducir el riesgo de sufrir complicaciones y mejorar nuestra salud en general.
Recuerda que la información proporcionada en este artículo es solo una guía básica y no reemplaza la consulta médica profesional. Si tienes síntomas persistentes o graves, te recomendamos buscar atención médica para recibir un diagnóstico y tratamiento adecuados.
Agradecemos por haber leído este artículo y esperamos que haya sido informativo y útil para ti. ¿Has tenido alguna experiencia con infecciones estomacales? ¿Tienes algún consejo adicional para prevenir estas enfermedades? ¡Déjanos tus comentarios y comparte tu opinión!
Si quieres conocer otros artículos parecidos a Tipos de infecciones estomacales puedes visitar la categoría Salud.

Conoce mas Tipos